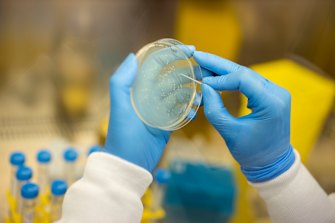
UQ has partnered with Moderna to develop mRNA vaccines for some of the world most devastating diseases.

The University of Queensland will join a global partnership with pharmaceutical company Moderna to produce mRNA vaccines for a range of the world’s most persistent and deadly diseases.
Earlier this week Moderna launched its “mRNA Access” program, which will open the company’s mRNA vaccine platform to research institutions around the world.
UQ has partnered with Moderna to develop mRNA vaccines for some of the world most devastating diseases.
The company was one of a handful that produced a viable vaccine against COVID-19 using mRNA technology, and it now wants researchers to use the technology to target other diseases that have been a problem for longer.
Mark Walker, who spearheaded the new partnership on the UQ side with fellow researcher Paul Young, said it was an incredible opportunity.
“Moderna are pushing out their technology platform, and we’re very interested in testing it out,” Professor Walker said.
“It’s not easy to make an mRNA vaccine from scratch, so we’re benefitting from Moderna’s expertise in mRNA vaccines, but reapplying that to other infections.”
Under the partnership, UQ researchers would use their expertise in particular pathogens to pick out the best antigens to trial, which Moderna would then apply to its mRNA platform, and which UQ would then develop for preclinical trials.
The technology sharing plan is part of Moderna’s global health strategy, in which is has pledged to launch vaccine programs for 15 diseases that pose a threat to low- and middle-income countries by 2025.
Among the diseases on Moderna and UQ’s hit list are dengue, malaria, tuberculosis and zika virus, which all disproportionately affect the developing world.
UQ partners with Moderna under global plan to develop mRNA vaccines
Source: Philippines Alive